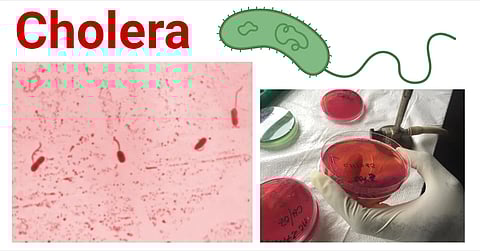

A CORRESPONDENT
DIBRUGARH: The health department confirmed a cholera outbreak in Dibrugarh district, identifying two confirmed cases and several suspected cases.
Dr Trishna Borah, Joint Director of Health Services in Dibrugarh, during a press briefing on Wednesday, said that the outbreak had been traced to the Pucca Line of Dinjoy tea estate in Chabua and Gazal Basti near Duliajan.
“There are two confirmed cholera cases based on tests from patient samples. As a result, we are treating all individuals presenting symptoms as likely cholera cases, although some may actually be suffering from gastroenteritis or diarrhea,” Dr Borah said.
Laboratory tests have confirmed high bacterial contamination in the tubewells of Paka Line, which have since been sealed. The area has also been declared under quarantine.
In view of the situation, the health department has issued an alert through the Integrated Disease Surveillance Programme (IDSP) in the affected areas of the district, while health teams have been deployed to carry out strict surveillance and preventive measures.
Intensive Information, Education and Communication (IEC) activities, including awareness campaigns through miking and interpersonal communication (IPC), are also being undertaken in both the affected areas.
Also Read: Maintain hygiene, urges doctor amid rising cholera cases: Medical Expert
Also Watch: